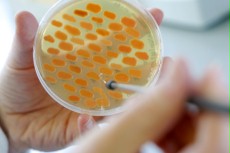

产品品牌瓦克
产品产地
产品型号L-Cysteine Free Base
包装规格
半胱氨酸
概述
L-半胱氨酸的传统工业生产方式是通过盐酸从毛发或羽毛中提取而得。瓦克研发的L-半胱氨酸生物技术工艺,能够通过发酵的形式,从葡萄糖和无机盐中提取氨基酸。代谢优化后的细菌(大肠杆菌)在该工艺中承担了合成的功能。通过有针对性地对细菌的新陈代谢进行分子生物学“手术”,首先促使细菌生产出远远大于自身需要的L-半胱氨酸,然后再促使细菌将这些L-半胱氨酸排入营养培养基。这样的代谢工程(metabolic engineering)能够防止杂质基因侵入细菌。瓦克持有该工艺多项 。瓦克生产的L-半胱氨酸为纯植物性,也适用于清真和犹太教食品,并符合欧洲药典(EP)、欧盟2000/63/EC号规定、美国药典(USP)、日本药典(JP)和食品化学法典(FCC)等所有重要食品及制药质量标准。L-半胱氨酸根据药品生产质量管理规范(GMP)进行生产,能够达到FCC和EP规定的很(zui)纯净要求。L-半胱氨酸尤其在生命科学领域用途广泛,在食品领域亦适用于清真和犹太教食品。

L-半胱氨酸拥有广泛的特性与功能。它能够断开肽和蛋白质中的二硫键,能够充当游离基清道夫,也可以用作还原剂。这些特性使L-半胱氨酸尤其能够在制药、化妆品、食品和膳食补充剂等领域获得广泛的应用。
在食品领域,L-半胱氨酸是生产调味香精的理想原料,常被用来生成肉味和烤香味。在制作面包或其他生面团时,加入L-半胱氨酸能够防止面粉里的面筋结团,使面团更易于揉捏。

在制药领域,L-半胱氨酸是生产N-乙酰-L-半胱氨酸和S-(羧甲基)-L-半胱氨酸这两种半胱氨酸衍生物很(zui)具经济性的原材料,两者都具有化痰止咳的临床功效。它们的SH基团——在S-(羧甲基)-L-半胱氨酸中的为活体内生成——能够断开支气管粘液所含蛋白质的二硫键,从而起到化痰的作用。很(zui)近,尤其在美国市场上,N-乙酰-L-半胱氨酸也被用作保健食品,这是因为L-半胱氨酸能够提高谷胱甘肽的含量,尤其对肝脏的氧化还原功能具有很好的促进作用。
L-半胱氨酸在制药业的第二大应用,是在对通过基因技术生产所得的蛋白质活性分子进行折叠时充当加工助剂。此类功能的氨基酸可用来生产人胰岛素等。这项应用也基于SH基团能够断开二硫键的能力,而这里是为之后对二硫键进行正确链接做准备。
此外,L-半胱氨酸也是药用蛋白质和肽的活性成分的结构单元,客户主要是一些需要先用它来生产受 保护的氨基酸,然后再继续生产肽合成物的厂家。
氨基酸还是生命科学另一领域──诊断应用──所需要的材料。它在这里被用作营养培养基的组分,用于培养细菌的琼脂板和培养液等。
很(zui)近,L-半胱氨酸在化妆品领域的作用也越来越重要。氨基酸被作为抗衰老剂用于一些化妆品,这是因为L-半胱氨酸具有游离基清道夫的功能,能够减缓皮肤等的衰老速度。L-半胱氨酸在化妆品领域的另一个应用主要在日本:那里的人们习惯在烫发前用它替代欧洲市场常见的、含有异味的巯基乙酸来对头发进行预处理。这种氨基酸能够断开头发中角蛋白的二硫键,疏松发丝结构,使头发更具可塑性。

L-半胱氨酸是20种天然氨基酸中的一种,也是惟一一种支链中含有氢巯基(巯基,–SH)的氨基酸。这些氢巯基团化学活性极强,生成的二硫键能够大大提高蛋白质的稳定性。(例如,人的头发和动物的绒毛、羽毛,以及人的指甲、动物的蹄和角中结构稳定的纤维原丝就是这样形成的,它们的蛋白质,即,角蛋白的大部分组分为半胱氨酸。)
Description: white powder or colourless crystals.L-Cysteine is one of the 20 natural amino acids and, besides methionine,the only one which contains sulfur. WACKER has developed a new production method for this amino acid via fermentation from non-animal and non-human raw materials.| 性质 | 测试方法 | 测试值 |
|---|---|---|
| 以上数据仅供参考,不用作制备规范。 | ||
| Solubility in water at 20 °C | 280 g/l | |
| pH | PH. EUR. (2.2.3) | 4.5 - 6 |
应用
保健食品成分
医药配方
结构单元
调味品
国务院印发《关于改革国有企业工资决定机制的意见》2018-05-28
国务院日前印发《关于改革国有企业工资决定机制的意见》(以下简称《意见》)。《意见》明确了改革的重点内容,一是改革工资总额决定机制。改革工资总额确定办法,完善工资与效益联动机制,分类确定工资效益联
泰国PTT计划新建区域性润滑油存储中心2018-03-26
据亚洲润滑油周报3月23日消息,泰国PTT润滑油公司表示,公司将为其东盟市场新建一个润滑油存储设施,同时将寻求收购标的实现其海外润滑油业务的增长。PTT润滑油公司将在泰国中部的北柳府新建该润滑油
石墨烯:那些我们不知道的本事2018-05-25
5月20~26日,2018年全国科技活动周暨北京科技周主场活动在中国人民革命军事博物馆举行。今年的科技周活动以“科技创新 强国富民”为主题,通过展品、展板、视频、动画、图片、实
田中贵金属扩大燃料电池用电极催化剂产能2018-07-10
7月10日,日本田中控股株式会社宣布田中贵金属工业株式会社将增设位于神奈川县的开发制造燃料电池用电极催化剂的FC催化剂开发中心。通过此次增设,可将目前的生产能力提高7倍,同时可满足面向燃料电池商
中石化欧Ⅴ汽油首供香港2018-08-16
8月12日,在广州石化珠江码头,装载着4500吨符合欧Ⅴ排放标准的98号无铅汽油的油轮启航运往香港,这是中国石化首次实现可持续向香港市场提供汽油,也标志着中国石化在香港47家油(气)站无内地生产
中国企业500强营收总额首次跃上70万亿元2018-09-03
2018年中国企业500强榜单2日在西安发布,500强企业营业总收入首次迈入70万亿元大关,达71.17万亿元,与上年相比增长11.2%。这一增速比上年提高了3.56个百分点。从榜单上看,国家电
为什么要用抗静电剂?抗静电剂是什么?2021-04-16
改性塑料常用的抗静电剂,抗静电剂如何消除静电危害2021-04-16
抗静电剂在各个领域的应用2021-05-27
纤维抗静电剂该如何选?工业除静电小技巧2021-05-27
静电的危害很大,所以无论是日常生活还在生产工作中我们都在想办法解决静电,那么消除静电的方法你知道有哪些吗?分为日常方法和工业抗静电剂。